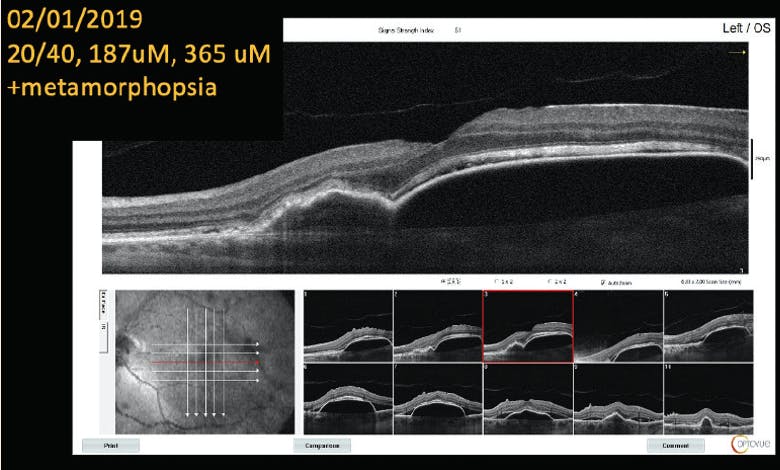

In-person meetings are paused during the COVID-19 pandemic, and finding places to gather information on our field’s trends may be difficult.

I sat down with Christopher G. Fuller, MD; Nikolas J.S. London, MD, FACS; and Christina Y. Weng, MD, MBA, to record a series of podcast episodes on New Retina Radio that capture the candid, professional nature of in-person conferences. It’s clear that as we look for solutions for patients, switching therapeutic agents is an option that we often employ. Each clinician has different standards for making these changes. We discussed the art of switching therapies for wet age-related macular degeneration (AMD) as illustrated in several cases, and also reviewed treatment strategies, pipeline data, and safety information.
Select portions of our discussion, edited for brevity and clarity, are below. To hear our extended discussion, including our review of pipeline developments, download and listen to our New Retina Radio miniseries, “Wet AMD: The Art of Drug Choice and the Latest Data.” To further dive into a video series of the cases presented in this text, visit Eyetube.net/series/the-art-of-drug-choice/.
—Arshad M. Khanani, MD, MA
AGENT CHOICE AND THE ART OF SWITCHING
Arshad M. Khanani, MD, MA: I’m curious to hear how the panelists approach patients with wet AMD in the COVID-19 era.
Christina Y. Weng, MD, MBA: Although the COVID-19 pandemic has been disruptive to our clinics in many ways, it has not significantly altered the way I treat wet AMD patients. Like many retina specialists, I generally use a treat-and-extend (TAE) regimen and have continued to do so.
Dr. Khanani: TAE therapy has been an effective regimen during the pandemic. How have you approached treatment-naïve patients during this time?
Nikolas J.S. London, MD, FACS: I agree with my copanelists and have continued to use a TAE regimen. I typically initiate treatment with an FDA-approved anti-VEGF agent, perform three monthly loading doses, then move toward TAE therapy, increasing the treatment interval in 1- to 2-week increments. One difference during the pandemic is that, in order to minimize office visits, I am less likely to switch patients to as-need therapy after they get out to q4 months or longer.
Dr. Khanani: When do you decide it may be time to switch anti-VEGF agents?
Dr. London: I don’t switch patients often. But if a patient has persistent, symptomatic intraretinal fluid after at least three injections with the same anti-VEGF agent, then I consider switching.
Dr. Khanani: What data points do you rely on to guide treatment?
Dr. London: I remind patients that visual acuity measurements should not be the only parameter we use in measuring success. We have other data points, such as OCT imaging and subjective visual changes. Patient satisfaction is an important data point in guiding treatment. I ask my patients if they’re happy with their overall visual function. If they are, then I weigh that against slight declines in visual acuity or the presence of subretinal fluid.
Christopher G. Fuller, MD: Patient empowerment is an inviolable tenet of my practice. I meticulously outline the risks and benefits of known interventions—including observation—and encourage the patient to make an informed decision. Some might call it laissez faire, but each of these free-willed encounters is really a trust-building activity. If disease activity worsens, my patients still feel in control as I guide their treatment, as they’ve had agency in their own care.
Dr. Khanani: That’s where the art of wet AMD management comes in. Understanding how to balance those data points is an inexact science.
Dr. Fuller: Very true, but there are certainly a handful of garden-variety scenarios in which switching anti-VEGF agents seems almost compulsory. These would include persistent intraretinal fluid, suspected tachyphylaxis, and a pattern of inexplicable visual decline.
A NEW ADDITION
Dr. Khanani: Clinicians commonly turn to anti-VEGF agents such as ranibizumab (Lucentis, Genentech), aflibercept (Eylea, Regeneron), or bevacizumab (Avastin, Genentech) for initial wet AMD therapy. They do so for good reason: the safety and success of these drugs has been well-documented. Still, not all patients respond to these therapies, and over time we may consider the possible benefits of other treatment options.
The recent approval of brolucizumab (Beovu, Novartis) for the treatment of wet AMD added another option to our armamentarium. How have you been using it in clinic?
Dr. Fuller: I love the concept and promise of durable therapy. Before the approval of brolucizumab, I estimate that 80% of my wet AMD patients received aflibercept, dozens of whom were maintained on quarterly injections without obvious retinal detriment. Given my love of durable therapy, I have been an enthusiastic brolucizumab convert, administering over 300 doses to date. A few of these patients have now cautiously been extended to 14 weeks while carefully watching for signs of inflammation.
Dr. Weng: Durability is the greatest unmet need right now. Development of long-duration injectables may be a solution. Gene therapy or a device that slowly delivers therapy such as the Port Delivery System (Genentech) could also be valuable.
Dr. Khanani: Even with monthly therapy, some of our patients do not respond optimally to anti-VEGF treatment even after exhausting all of the anti-VEGF agents available to us.
Dr. Weng: And that’s a big problem. Management of those patients is a challenge, as dosing them more often than monthly is not feasible for multiple reasons. As much as we talk about longer-durability anti-VEGF agents, just having another anti-VEGF option for patients who have not responded to existing agents could be a major development for our refractory patients. From this standpoint, having more therapeutic options is beneficial.
SAFETY AND INFLAMMATION IN WET AMD THERAPY
Dr. Khanani: Weighing risks against benefits is one of the leading challenges that retina specialists face. Many retina specialists are aware of the safety profiles of the three commonly used anti-VEGF agents at our disposal, but new data about safety regarding brolucizumab may not be as familiar.
Dr. Weng, can you tell us about some of the real-world safety considerations for the use of brolucizumab?
Dr. Weng: In the phase 3 HAWK and HARRIER trials that evaluated the safety and efficacy of brolucizumab for the treatment of wet AMD, researchers did not report any cases of retinal vasculitis.1 Aside from ocular inflammation, rates of adverse events were similar among the treatment and comparison arms.
In real-world settings, instances of inflammation,2 vasculitis,3 and arterial occlusions4 were reported. As of September 2020, the reported postmarketing event rate for retinal vasculitis was 4.5 per 10,000, and the rate of retinal vascular occlusion was 3.0 per 10,000 injections.5 An independent safety review committee identified a rate of 4.6% of intraocular inflammation (IOI) of all types and estimated that the risk of developing IOI of any form and losing at least 15 letters was 0.7%.6
Dr. Khanani: Monitoring these patients is key. Dr. Fuller, how do you monitor patients who are undergoing brolucizumab therapy?
Dr. Fuller: Many of my patients can access me directly via text, and all have been instructed to do so with unexpected vision loss, discomfort, or disconcerting floaters.
Dr. London: After administering brolucizumab, I ask new patients to return in a week to examine them for signs of inflammation. I am hoping to catch any inflammation early. Also, I gather imaging data from my patients. I have found ultrawide-field color fundus photography (Optos) to be a useful modality.
Dr. Weng: Some patients may have a higher risk tolerance, particularly if their disease has been refractory to other treatment options. Weighing the risk-benefit ratio in our more challenging cases is part of the art of medicine.
Dr. Khanani: Dr. Weng is right: the balancing act of retina practice comes into focus when we manage complex cases.
Case 1: Steroids in Wet AMD and CME
By Christopher G. Fuller, MD
Patient History:
- 81-year-old man, monocular, diagnosed with wet age-related macular degeneration (AMD) in 2014
- VA was 20/40 OD for 5 years, largely maintained on variable (monthly or bimonthly) bevacizumab (Avastin, Genentech) therapy
- Presented to clinic in September 2018 discomfited by recent vision loss (20/80)
Intervention:
- Monthly aflibercept (Eylea, Regeneron) and bevacizumab therapy were ineffectual; VA further dropped to 20/200.
- OCT confirmed worsening cystoid macular edema (CME).
- An intravitreal dexamethasone implant 0.7 mg (intravitreal dexamethasone implant (IDI); Ozurdex, Allergan) was administered (Figure 1). Eight days later, anatomy and VA (20/60) were much improved (Figure 2).
- Thereafter, IDI was administered with bevacizumab for 1 year (at approximately quarterly intervals), with good results.
- Subsequently, the patient has received a combination of IDI and/or bevacizumab, aflibercept, or brolucizumab (Beovu, Novartis) at each visit.
- Patient is currently 20/50, happily “dry”, and has received six IDI injections to date (Figure 3).

Figure 1. When VA dipped to 20/200 OD, IDI therapy was administered in the speculative hopes of diminishing the CME present.

Figure 2. Eight days after administration of IDI #1, VA quickly rebounded to 20/60, and anatomic normalization was impressive and complete.

Figure 3. The patient’s baseline macular architecture has been largely restored and maintained with a combination of IDI and anti-VEGF therapy.
Discussion:
Christina Y. Weng, MD, MBA: I applaud you for thinking outside the box on this case. It is not often that we see IDI therapy used in wet AMD treatment, especially when administered alongside anti-VEGF therapy. Dr. Fuller, did you consider another etiology for the patient’s CME?
Dr. Fuller: Indeed I did. However, angiography was not suggestive of other vasculopathies (eg, retinal vascular occlusive disease) that would account for his intraretinal fluid. The patient does have longstanding cellophane maculopathy, but of a mild sort that is not commensurate with the edema present.
Arshad M. Khanani, MD, MA: I am glad you ruled out other etiologies of CME, as the patient might have had concurrent retinal vein occlusion and wet AMD. It also highlights the fact that controlling inflammation in some patients with wet AMD can be important.
Case 2: Reducing Burden in Wet AMD
By Christina Y. Weng, MD, MBA
Patient History:
- 80-year-old woman with a 10-year history of dry age-related macular degeneration (AMD)
- Visits every 6 months for evaluation with consistent 20/25 VA
- Patient reports visual loss OD. VA of 20/60 OD and subretinal fluid (SRF) are documented (Figure 1).

Figure 1. After presenting every 6 months with consistent 20/25 VA (left panel), the patient presented with 20/60 VA and new SRF (right panel).
Intervention:
- Monthly aflibercept (Eylea, Regeneron) was administered for 3 months. VA improved to 20/40 OD, and SRF decreased but persisted (Figure 2, left panel). The patient asked if a new drug, which she heard reduces treatment burden, was an option.
- Brolucizumab (Beovu, Novartis) was administered after a conversation with the patient about risks of intraocular inflammation (IOI).
- A month later, VA improved to 20/30, and SRF had resolved (Figure 2, right panel).
- Brolucizumab was administered again after an interval of 8 weeks and again after 12 weeks. The patient remains stable at 20/30 VA with no signs of IOI.

Figure 2. After three monthly doses of aflibercept (left panel), the patient responded well to brolucizumab therapy (right panel).
Discussion:
Arshad M. Khanani, MD, MA: This case illustrates the superior drying effect of brolucizumab compared with other anti-VEGF agents. Due to rare safety events of vasculitis and retinal artery occlusions associated with brolucizumab in patients undergoing anti-VEGF therapy, I perform a meticulous dilated fundus exam during each visit. Also, the patient is given instructions to call the office, if any visual disturbances occur.
Dr. Weng: I did not re-load the patient with brolucizumab, partly because I do not typically do so when switching between anti-VEGF drugs and partly because the timing coincided with the start of the COVID-19 pandemic. Dr. Fuller, would you have done otherwise?
Christopher G. Fuller, MD: I typically consider loading doses in a treatment-naïve patient. In a patient who has exhibited a previous response to anti-VEGF therapy, however, I am quick to extend the treatment interval (without loading), especially when switching to a more “durable” drug. The cynic in me has long been wary of expecting different results when engaged in any sort of ritualistic therapy that falls flat the first time.
Nikolas J.S. London, MD, FACS: It’s interesting that the patient requested a switch to a potentially more durable drug she heard about. Whenever a patient requests a specific drug, I use that as an opportunity to educate them about all of the options. If, after that conversation, they believe a particular treatment is warranted, I typically honor their request as long as I think the choice will be safe and effective.
Case 3: PED, Metamorphopsia, and Wet AMD
By Nikolas J.S. London, MD, FACS
Patient History:
- 70-year-old white man who lives 4 hours from the office
- Patient presented with 20/40 VA OS. Significant, symptomatic metamorphopsia was noted, associated with a large pigment epithelial detachment (PED; Figure 1).
Intervention:
- Monthly ranibizumab (Lucentis, Genentech) therapy was initiated. No significant changes were observed after four doses.
- At month 5, bevacizumab (Avastin, Genentech) was delivered. No change was observed after therapy.
- Aflibercept (Eylea, Regeneron) was administered during six monthly visits. No change was observed (Figure 2).
- After a discussion with the patient about treatment options, brolucizumab (Beovu, Novartis) therapy was initiated.
- After two monthly doses, the patient’s anatomy and metamorphopsia resolved, and VA was 20/30 (Figure 3). The patient was ecstatic about his vision and insisted on continuing brolucizumab therapy despite new safety concerns.
- For the past 6 months, the patient has visited the office every 8 weeks for brolucizumab therapy. Visual acuity and symptoms remain stable. However, he appears to be developing recurrent PED and subretinal fluid at the 8-week interval, and we will need to explore other options going forward. He has received seven injections of brolucizumab.

Figure 2. After 11 monthly doses of various anti-VEGF agents, the patient’s condition remained largely unchanged.

Figure 3. After two injections of brolucizumab, the patient’s PED resolved, and VA improved to 20/30.
Discussion
Arshad M. Khanani, MD, MA: This is an example of how brolucizumab may be an effective therapy in patients who have shown suboptimal response to other anti-VEGF agents.
Christina Y. Weng, MD, MBA: The fact that q8 week dosing in this patient is barely enough to get him to his next appointment reminds us that there are some patients who require more frequent dosing than what a drug’s label indicates.
Christopher G. Fuller, MD: Dr. London should be commended for his management of this case. Recalcitrant, outsized PEDs are veritable ticking time bombs. One is wise to beware an RPE rip while staying cognizant that inattention might usher in far larger hemorrhages.
CONCLUSION
Dr. Khanani: Retina specialists are tasked with applying clinical data to real-world cases. In this sense we have two roles: scientist and artist. The art of drug choice for our patients often allows clinicians to exercise both the left brain’s analytic capacity and the right brain’s creativity. By employing collaboration between art and science, we can often optimize results and limit vision loss for our patients.
1. Dugel PU, Koh A, Ogura Y, HAWK and HARRIER Study Investigators. HAWK and HARRIER: Phase 3, multicenter, randomized, double-masked trials of brolucizumab for neovascular age-related macular degeneration. Ophthalmology. 2020;127(1):72-84.
2. Baumal CR, Spaide RF, Vajzovic L, et al. Retinal vasculitis and intraocular inflammation after intravitreal injection of brolucizumab. Ophthalmology. 2020;127(10):1345-1359.
3. Witkin AJ, Hahn P, Murray TG. Occlusive retinal vasculitis following intravitreal brolucizumab. J Vitreoretin Dis. 2020;4(4):269-279.
4. Jain A, Chea S, Matsumiya, et al. Severe vision loss secondary to retinal arteriolar occlusions after multiple intravitreal brolucizumab administrations. Am J Ophthalmol Case Rep. 2020;18:100687.
5. Post-marketing Data. Available at: brolucizumab.info/post-marketing-data. Accessed: October 20, 2020.
6. American Society of Retina Specialists. ASRS Clinical Update. Member Update: Novartis-Appointed Safety Review Committee. Available at: asrs.org/clinical/clinical-updates/4013/Member-Update-Novartis-Appointed-Safety-Review-Committee-Reports-Initial-Broluci. Accessed: October 20, 2020.